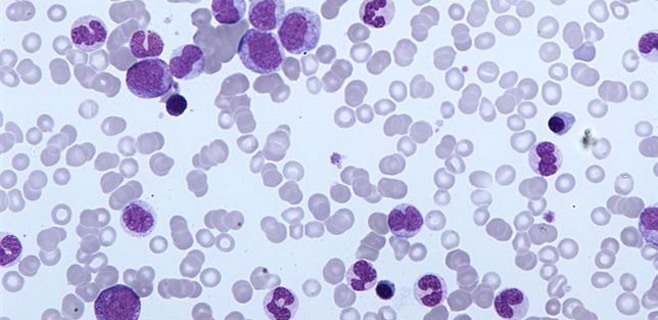

El término cáncer engloba un grupo numeroso de enfermedades que se caracterizan por el desarrollo de células anormales, que se dividen y crecen en cualquier parte del cuerpo. Encontrar una cura es uno de los retos médicos más importantes y conseguir que esa cura neutralice las células cancerosas es un sueño que, en el futuro, podría significar uno de los pilares del tratamiento de estas enfermedades.
Esto es lo que han conseguido investigadores de la Escuela de Medicina de la Universidad de Stanford, en Palo Alto, California, Estados Unidos, en un modelo animal y en un tipo de cáncer concreto: la leucemia linfoblástica. Han descubierto que cuando esta leucemia, que es muy agresiva, está causando estragos en el cuerpo, la solución puede ser obligar a las células cancerosas a crecer y portarse bien. Tras una observación casual en el laboratorio, los investigadores encontraron un método que puede hacer que las células de leucemia peligrosas maduren y se conviertan en células inmunes inofensivas conocidas como macrófagos.
La leucemia linfoblástica aguda de células B con una mutación llamada cromosoma Filadelfia es un cáncer particularmente agresivo con malos resultados, explica uno de los autores de este trabajo, Ravi Majeti, profesor asistente de Medicina y autor principal del artículo sobre el estudio que se publica en la edición digital de este lunes de 'Proceedings of the National Academy of Sciences'. Por ello, encontrar posibles tratamientos es particularmente positivo. Majeti y sus colegas hicieron la observación clave después de recoger células de leucemia de un paciente y tratando de mantener las células vivas en una placa de cultivo. "Les echamos de todo para ayudarlas a sobrevivir", relata Majeti, quien también es miembro del Instituto de Cáncer de Stanford y el Instituto de Biología de Células Madre y Medicina Regenerativa de Stanford.
Algunas de las células cancerosas en cultivo fueron cambiando de forma y tamaño a lo que parecía macrófagos, subraya otro de los autores principales del artículo, Scott McClellan. Las razones por las que cambiaron las células eran un misterio hasta que Majeti recordó un trabajo de investigación antiguo, que mostró que las células progenitoras de células B de ratón podían forzarse para convertirse en macrófagos cuando se exponen a ciertos factores de transcripción, proteínas que se unen a ciertas secuencias de ADN. "Células de la leucemia de células B son en muchas formas células progenitoras que se ven obligadas a permanecer en un estado inmaduro", explica Majeti.
Así que, McClellan y el estudiante Christopher Dove, estudiante de doctorado y otro autor principal del trabajo, hicieron más experimentos y confirmaron que métodos que mostraron haber alterado el destino de las células progenitoras del ratón hace años podrían utilizarse para transformar estas células de cáncer humano en macrófagos, que pueden tragar y digerir las células cancerosas y los patógenos. Majeti y sus colegas tienen razones para esperar que cuando las células cancerosas se conviertan en macrófagos no sólo sean neutralizadas, sino que en realidad pueden ayudar en la lucha contra el cáncer. Las células macrófagos presentan trozos reconocibles de células anormales a otras células inmunitarias para que puedan lanzar un ataque. "Como las células macrófagos proceden de células cancerosas, ya llevan con ellas las señales químicas que identificarán las células cancerosas, lo que hace que se más probable un ataque inmune contra el cáncer", augura Majeti.
Los próximos pasos de los investigadores serán ver si pueden encontrar un medicamento que promueva la misma reacción y que podría servir de base para una terapia contra la leucemia. Hay un precedente de este tratamiento: el ácido retinoico que se utiliza comúnmente para tratar otro tipo de cáncer llamado leucemia promielocítica aguda. En ese caso, el ácido retinoico se emplea para activar las células cancerosas en células maduras llamados granulocitos. Este tratamiento es la única terapia bien establecida que madura, o "diferencia" las células cancerosas, pero los investigadores de todo el mundo tienen la esperanza de encontrar muchos más. "Hay un gran interés en las terapias de diferenciación para el cáncer", concluye Majeti.